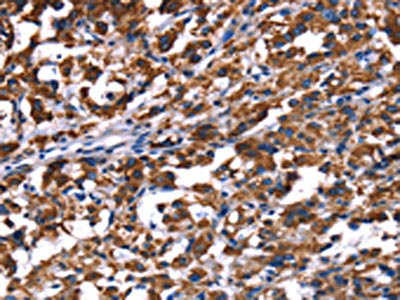

PHB Antibody
-
中文名稱:PHB兔多克隆抗體
-
貨號:CSB-PA926901
-
規(guī)格:¥1100
-
圖片:
-
The image on the left is immunohistochemistry of paraffin-embedded Human liver cancer tissue using CSB-PA926901(PHB Antibody) at dilution 1/30, on the right is treated with fusion protein. (Original magnification: ×200)
-
The image on the left is immunohistochemistry of paraffin-embedded Human thyroid cancer tissue using CSB-PA926901(PHB Antibody) at dilution 1/30, on the right is treated with fusion protein. (Original magnification: ×200)
-
Gel: 10%SDS-PAGE, Lysate: 40 μg, Lane 1-7: 293T cells, A549 cells, human liver cancer tissue, PC3 cells, human placenta tissue, hela cells, mouse heart tissue, Primary antibody: CSB-PA926901(PHB Antibody) at dilution 1/350, Secondary antibody: Goat anti rabbit IgG at 1/8000 dilution, Exposure time: 15 seconds
-
-
其他:
產(chǎn)品詳情
-
Uniprot No.:
-
基因名:PHB
-
別名:Epididymis luminal protein 215 antibody; Epididymis secretory sperm binding protein Li 54e antibody; HEL 215 antibody; HEL S 54e antibody; PHB antibody; PHB_HUMAN antibody; PHB1 antibody; Prohibitin antibody
-
宿主:Rabbit
-
反應(yīng)種屬:Human,Mouse,Rat
-
免疫原:Fusion protein of Human PHB
-
免疫原種屬:Homo sapiens (Human)
-
標(biāo)記方式:Non-conjugated
-
抗體亞型:IgG
-
純化方式:Antigen affinity purification
-
濃度:It differs from different batches. Please contact us to confirm it.
-
保存緩沖液:-20°C, pH7.4 PBS, 0.05% NaN3, 40% Glycerol
-
產(chǎn)品提供形式:Liquid
-
應(yīng)用范圍:ELISA,WB,IHC
-
推薦稀釋比:
Application Recommended Dilution ELISA 1:2000-1:5000 WB 1:500-1:2000 IHC 1:50-1:200 -
Protocols:
-
儲存條件:Upon receipt, store at -20°C or -80°C. Avoid repeated freeze.
-
貨期:Basically, we can dispatch the products out in 1-3 working days after receiving your orders. Delivery time maybe differs from different purchasing way or location, please kindly consult your local distributors for specific delivery time.
-
用途:For Research Use Only. Not for use in diagnostic or therapeutic procedures.
相關(guān)產(chǎn)品
靶點(diǎn)詳情
-
功能:Protein with pleiotropic attributes mediated in a cell-compartment- and tissue-specific manner, which include the plasma membrane-associated cell signaling functions, mitochondrial chaperone, and transcriptional co-regulator of transcription factors in the nucleus. Plays a role in adipose tissue and glucose Homeostasis in a sex-specific manner. Contributes to pulmonary vascular remodeling by accelerating proliferation of pulmonary arterial smooth muscle cells.; In the mitochondria, together with PHB2, forms large ring complexes (prohibitin complexes) in the inner mitochondrial membrane (IMM) and functions as chaperone protein that stabilizes mitochondrial respiratory enzymes and maintains mitochondrial integrity in the IMM, which is required for mitochondrial morphogenesis, neuronal survival, and normal lifespan (Probable). The prohibitin complex, with DNAJC19, regulates cardiolipin remodeling and the protein turnover of OMA1 in a cardiolipin-binding manner. Regulates mitochondrial respiration activity playing a role in cellular aging. The prohibitin complex plays a role of mitophagy receptor involved in targeting mitochondria for autophagic degradation. Involved in mitochondrial-mediated antiviral innate immunity, activates DDX58/RIG-I-mediated signal transduction and production of IFNB1 and proinflammatory cytokine IL6.; In the nucleus, acts as a transcription coregulator, enhances promoter binding by TP53, a transcription factor it activates, but reduces the promoter binding by E2F1, a transcription factor it represses. Interacts with STAT3 to affect IL17 secretion in T-helper Th17 cells.; In the plasma membrane, cooperates with CD86 to mediate CD86-signaling in B lymphocytes that regulates the level of IgG1 produced through the activation of distal signaling intermediates. Upon CD40 engagement, required to activate NF-kappa-B signaling pathway via phospholipase C and protein kinase C activation.
-
基因功能參考文獻(xiàn):
- prohibitin is an important negotiator protein that regulates dopaminergic cell death in substantia nigra and their protection in ventral tegmental area in Parkinson's Disease. PMID: 28062948
- Results show that PHB expression is significantly increased in metastatic prostate cancer and represents a strong marker predicting survival, along with ALDH6A1 and HSP27. PMID: 30396985
- Data suggest that prohibitin (PHB) plays a crucial role in integrating cell signaling events with metabolic switches, and may serve as a potential target for cancer immunotherapeutic [Review]. PMID: 29222040
- prohibitin 1 regulates tumor cell apoptosis via the interaction with X-linked inhibitor of apoptosis protein PMID: 27025967
- Up regulation of PHB in relapsing vs remission MS patients imply the potential use of PHB to clinically evaluate subclinical disease status towards prognosis of an oncoming relapse PMID: 29242126
- Study gives attention to the functional role and regulatory mechanism of PHB proteins in cardiovascular health and diseases (VCD) and its associated implications. Various molecular pathways involved in PHB function and its regulation are analyzed. In neoplasm, PHB is shown to act through many mechanisms by acting as oncogene, tumor suppressor, antioxidant, antiapoptotic, in angiogenesis, autophagy etc. [review] PMID: 27557820
- This study support the role of miR-195 as anti-proliferative miRNA via targeting of PHB1 in melanoma cells PMID: 29126391
- Data (including data from studies using knockout mice) suggest that cell surface-expressed PHB is involved in Enterovirus 71 entry into neuronal cells; mitochondrial membrane-bound PHB associates with virus replication complex and facilitates viral replication. PMID: 29324904
- The G to A transition but not the C-to-T transition in the 3'-UTR of prohibitin was associated with an increased risk of gastric cancer in Chinese population. PMID: 28294412
- Case Report: imbalance between ROS and antioxidants together with failure of signal transduction in the glomerular slit membrane caused by prohibitin 2 abnormality could have contributed to nephrotic syndrome. PMID: 27812762
- Study elucidates an important role of PHBP1 in promoting esophageal squamous cell carcinoma partly via increasing PHB expression. PMID: 28404970
- Endoplasmic reticulum resident chaperone GRP78, mitochondrial protein Prohibitin and heterogeneous nuclear ribonucleoprotein hnRNPC (C1/C2) have been shown to interact with viral RNA. Hence it is proposed that these are the principle candidates governing endoplasmic reticulum stress-induced apoptosis in JEV infection. PMID: 28102850
- PHB1 down regulation suppresses liver cancer and bile duct cancer tumorigenesis. PMID: 27981602
- PHB has an unexpected nuclear role in human embryonic stem cells that is required for self-renewal and that it acts with HIRA in chromatin organization to link epigenetic organization to a metabolic circuit. PMID: 27939217
- results demonstrate that the H19-Igf2 axis is negatively regulated by CTCF-PHB1 cooperation and that H19 is involved in modulating the growth-suppressive effect of PHB1 in the liver. PMID: 27687727
- PHB promotes AR activation in ER-positive breast cancer. PMID: 28272969
- High PHB expression is associated with breast cancer. PMID: 27485113
- Data shows that PHB protein was overexpressed in gallbladder cancer tissues and significantly associated with histological grade, tumor stage and perineural invasion. PMID: 27084680
- The present review focus is on recent developments in prohibitin (PHB) research in relation to ovarian granulosa cells physiological functions. [review] PMID: 26496733
- We propose a model whereby in analogy to previous findings (e.g., the RAS-RAF signalling pathway), PHB can act as a signalling scaffold protein to assist in KDELR-dependent Src activation PMID: 26064897
- a majority of patients with IgG4-related disease have antibodies against prohibitin. PMID: 25932630
- PHB phosphorylated at threonine 258 and MIG-7 may play complementary roles in the initiation and sustainment of the effects of growth factors and COX-2/PGE2 on cancer invasion/metastasis. PMID: 25575814
- miR-27a was shown to be a significant tumor suppressor by targeting and decreasing PHB protein expression in glioma U251 cells. miR-27a targeting of PHB may be a novel potential therapeutic strategy for glioma PMID: 25777779
- Less expression of prohibitin is associated with increased paired box 2 in renal interstitial fibrosis PMID: 22949832
- A protective role of PHB that is dependent on pS727-Stat3 to prevent mitochondrial dysfunction in intestinal epithelial cells. PMID: 24975845
- Knockdown of prohibitin expression promotes glucose metabolism in eutopic endometrial stromal cells from women with endometriosis. PMID: 25444511
- we have provided a modified method for isolating and identifying membrane proteins and demonstrated that PHB1 may be a promising biomarker for early diagnosis and therapy of pancreatic (and potentially other) cancers. PMID: 25344214
- PHB lies downstream of ERalpha and mediates estrogen-dependent Paclitaxel resistance signaling cascades PMID: 24376711
- The study suggest that the tumor suppressing action of prohibitin is probably associated with luteinizing hormone mediated protection role against ovarian epithelial carcinoma. PMID: 24966933
- The T allele of the rs6917 polymorphism was associated with reduced PHB mRNA levels. PMID: 24879411
- Findings provide new insights into the function of prohibitin in transcriptional regulation and uncover a BASP1-prohibitin complex that plays an essential role in the PIP2-dependent recruitment of chromatin remodeling activities to the promoter. PMID: 24166496
- Vi released by Salmonella typhi interacts with the membrane prohibitin complex and inhibits IL-2 secretion from T cells stimulated through the T-cell receptor (TCR). PMID: 24470505
- PHB expression was crucial for maintenance of oncogenic ERK-driven pancreatic tumorigenesis PMID: 24568222
- Results of the present study confirmed that the expression and distribution of PHB, which is a nuclear matrix protein, affect the apoptosis of HaCaT cells PMID: 24402549
- Amplification at 17q21.33 is a recurrent feature of breast cancer that forms part of a 'firestorm' pattern of genomic aberration. PHB is not a driver of amplification, however PHB may contribute to high grade breast cancer. PMID: 24247619
- Persistent PAR1 signaling due to the absence of membrane PHB and decreased PAR1 degradation caused by the upregulation of intracellular PHB in cancer cells may render them highly invasive. PMID: 24732013
- The different subcellular localization of PHB1 in non-small cell lung cancer cells and the loss of the membrane-associated PHB1 probably related to the tumorigenesis and progression of NSCLC. PHB1 may play different roles in various types of NSCLC. PMID: 24133587
- Prohibitin is regulated by miR-26a and promotes glioma progression and angiogenesis. PMID: 23870455
- Prohibitin may be associated with breast cancer. PMID: 23715748
- Studies indicate that in response to stimulation with antigen, PHB1 translocated to plasma membrane lipid rafts to form a ternary complex with the high-affinity IgE receptor FcepsilonRIgamma and the nonreceptor tyrosine kinase Syk. PMID: 24023253
- prohibitin and prohibiton (PHB2) contribute to PIG3-mediated apoptosis by binding to the PIG3 promoter (TGYCC)15 motif PMID: 24388982
- These results suggest that the altered localization and expression of PHB, as well as its co-localization with related oncogenes and tumor suppressor genes, can affect the apoptosis of Mz-ChA-1 cells. PMID: 24380853
- Our data suggest that miR-27 is an anti-adipogenic microRNA partly by targeting prohibitin and impairing mitochondrial function. PMID: 24133204
- Decreased expression of prohibitin protein is closely associated with poor prognosis and metastasis in nasopharyngeal carcinoma. PMID: 22728421
- PHBs are localized on the human platelet membrane and are involved in PAR1-mediated platelet aggregation. PMID: 22212092
- Here, we review the signal transduction pathways of PHB and its role in the pathogenesis of diseases. PMID: 23327602
- Calreticulin and prohibitin were identified to be novel candidate biomarkers for adrenocortical carcinomas. PMID: 23587357
- Six investigations were identified for the analysis of association between the prohibitin 3' untranslated region C > T gene polymorphism and cancer risk. PMID: 22994754
- Missense mutation in prohibitin may be associated with breast tumor development and/or progression. PMID: 23244120
- In schizophrenia, there were significantly more prohibitin-expressing oligodendrocytes in the right dorsolateral white matter area, suggesting involvement in mitochondrial and/or cell-cycle dysfunction. PMID: 22711522
顯示更多
收起更多
-
亞細(xì)胞定位:Mitochondrion inner membrane. Nucleus. Cytoplasm. Cell membrane.
-
蛋白家族:Prohibitin family
-
組織特異性:Widely expressed in different tissues.
-
數(shù)據(jù)庫鏈接:
Most popular with customers
-
-
YWHAB Recombinant Monoclonal Antibody
Applications: ELISA, WB, IHC, IF, FC
Species Reactivity: Human, Mouse, Rat
-
Phospho-YAP1 (S127) Recombinant Monoclonal Antibody
Applications: ELISA, WB, IHC
Species Reactivity: Human
-
-
-
-
-